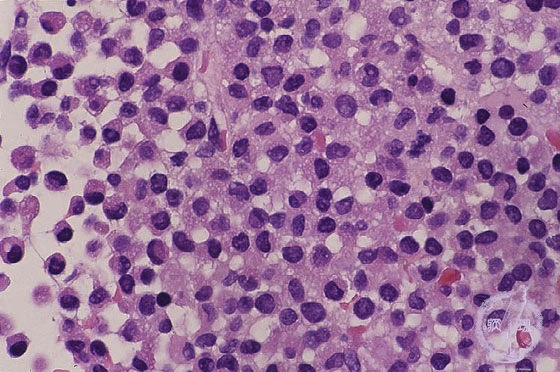

- 1.Bone marrow / Hematopoietic system
- ★(5) Acute myeloid leukemia(M3)
Microscopic image (H&E high power view): Acute promyelocytic leukemia (M3). Diffuse proliferation of myeloblasts is found. This type of leukemia sometimes form green nodules, therefore it was called as “chloroma”. Notoriously, it often causes disseminated intravascular coagulation (DIC).
Click the image to see the enlarged image.














